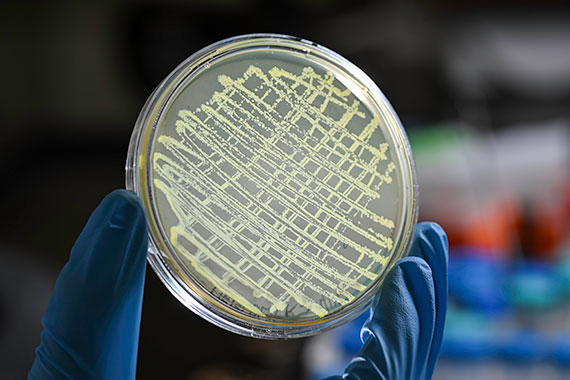
A gloved hand holds a petri dish of bacteria.

November 10, 2025

University of Rochester photo / J. Adam Fenster
Dear members of the Hajim School community,
Tomorrow marks Veterans Day, a holiday where we honor military veterans of the US Armed Forces for their dedicated service to our country. The University will celebrate with the annual Veterans Day 5K hosted by the Veterans Alliance and the University’s Naval Reserve Officers Training Corps (NROTC) unit.
For eight decades, the NROTC program has prepared college students to become officers in the US Navy or Marines through academics, physical training, and leadership development. Our NROTC students give so much to the URochester community, and you can learn more about the program’s 80-year history at the News Center.
DAVID FOSTER EARNS THE UNIVERSITY’S HIGHEST AWARD FOR TEACHING

University of Rochester photo / J. Adam Fenster
Congratulations to Professor David Foster from the Department of Chemical and Sustainability Engineering, who was presented last week with the Goergen Award for Excellence in Undergraduate Teaching. Dave taught his first classes as an adjunct professor in 2001 and dove into full-time teaching in 2013 as an instructional track professor, becoming a beloved fixture of the department.
Drawing from a decorated career at Eastman Kodak Company as one of the principal research scientists responsible for the components used in thermal printing, Dave provides his students industry experience, rigorous theoretical knowledge, and a fierce advocate.
Read about what makes Dave such a wonderful professor at the News Center.
RICK CARL ’19, ’20 (MS) BLENDS CREATIVITY AND ENGINEERING IN SYNTH DESIGN

University of Rochester photo / J. Adam Fenster
The audio music and engineering (AME) program recently cut the ribbon on a state-of-the-art synthesizer lab in the Computer Studies Building, and we’re proud that it features the creations of a distinguished young alumnus.
Rick Carl ’19 (AME), ’20 (MS, electrical and computer engineering), a hardware engineer at Moog Music Inc., is deeply involved in the product design for new instruments. His designs—including the Moog Labyrinth and the Moog Muse synthesizers—have received critical acclaim and will now be used to help to train the next generation of AME students at URochester.
Read about Rick’s fascinating career and how he found the perfect fit at URochester to help him earn his dream job.
IGEM TEAM RECEIVES MORE AWARDS THAN ANY OTHER US COLLEGE TEAM
University of Rochester photo / J. Adam Fenster
A team of 14 URochester students earned top honors at the 2025 International Genetically Engineered Machine (iGEM) competition, where the team was the number one most-recognized college team in the United States! Their project, dubbed “PHAntom,” aims to use bacteria to transform carbon dioxide into materials that may one day help astronauts build a sustainable life on Mars.
In October, Team PHAntom submitted their research to the 2025 iGEM competition, a global event where student teams tackle real-world challenges using synthetic biology—a field that applies engineering principles to create biological systems inspired by nature. The URochester team competed against 421 teams worldwide and was awarded a gold medal and four nominations in categories including “Best Space Project” and “Best Hardware” for their innovative approaches. With these honors, the team received more awards than any other college team in the US.
Congratulations to the students from the Hajim School and School of Arts and Sciences who participated! Learn more about their project at the News Center.
DANAE POLSIN AWARDED NEIL ASHCROFT EARLY CAREER AWARD BY APS

Congratulations to Danae Polsin, an assistant professor of mechanical engineering and staff scientist at the Laboratory for Laser Energetics, who has been awarded the 2026 Neil Ashcroft Early Career Award by the American Physical Society.
This prestigious honor recognizes her groundbreaking contributions to high-pressure physics, including her innovative experimental techniques that explore the behavior of materials under extreme conditions. In addition to her exceptional research, Professor Polsin is a dedicated mentor, inspiring and guiding the next generation of scientists.
Read about the honor on the LLE website.
NEIL ZHANG EARNS BEST STUDENT PAPER AWARD AT IEEE WASPAA 2025

Congratulations to You (Neil) Zhang, an electrical and computer engineering PhD student who won a Best Student Paper Award at IEEE WASPAA 2025! His research focused on head-related transfer functions, which describe how sound is changed by the ear, head, and torso of a listener as it travels from the sound source to ear canals.
Neil is advised by Professor Zhiyao Duan and the paper was a collaboration with Meta Reality Labs Research and University of Maryland College Park. Neil reflected on his award -winning project in a blog post on LinkedIn.
SIX STUDENTS WIN AWARDS AT THE AICHE NATIONAL CONFERENCE

The Department of Chemical and Sustainability Engineering proudly sent 19 undergraduate students to the recent AIChE Annual Meeting to compete in the 2025 Undergraduate Student Poster Competition. This year’s event featured about 560 participants from universities around the world, each selected after submitting abstracts and earning approval to present in multiple categories. Six of our students earned awards for their outstanding poster presentations and research contributions. Their names and poster titles are:
- Jack Collings ’26: “Using CFD to Model Fluid Flow in Steam Ejector”
- Chauner Clausing ’27: “Modeling Gene Circuit Dynamics: An Educational Toolkit Integrating Modular Hardware and Predictive Software”
- Simon Krasnow ’27: “Coating WERS Photonics Chips Using Semi‐Contact Nanoliter Droplet Printing“
- Jay-Brian Randone ’26: “ML‐Guided Genetic Algorithm for Designing CO2 Selective Polymer Membranes“
- Courtney Palmeri ’26: “Desalinating Saltwater with a Reverse Osmosis Membrane Apparatus“
- Kaiyue (Susie) Wang ’27: “Impact of Surface Chemistry on Photocatalytic Activity of Spinel Ferrite Nanocrystals“
HAJIM STUDENTS CRACK THE CODE AT THE HEIST HACKATHON

I’m pleased to share that Hajim School students fared very well at the Ain Center’s The Heist Hackathon. The competition featured 55 Hajim, SAS, and Simon students, on 14 teams competing to break into real-world problems and unlock bold solutions at the intersection of AI and entrepreneurship.
- The Grand Prize (The Master Key), which included a $1,500 prize and Foundry membership awarded to the best overall project, went to Team CarOS, a car diagnostic that can help you fix your car via an AI mechanic and/or suggest locations where your car can be fixed:
- Reward Mulauzi ’27 (chemical engineering)
- Tamuda Chimhanda ’26 (computer science)
- The Best Technical Execution award, which included a $500 prize and meeting with Hajim faculty went to Team Merak, an AI agent marketplace that recommends the best option with AI:
- Ayush Pandey ’27 (economics)
- Eray Bozoglu ’27 (computer science and economics)
- Ahmet Latif Colak ’27 (computer science)
- Can Afaraci ’28 (computer science)
- The Best Entrepreneurial Vision award went to Team Sensory, a mental health AI app:
- Caleb Lee ’27 (microbiology)
- Esther Hou ’27 (chemical engineering)
- Michael Ng ’26 (chemical engineering)
BECKMAN FOUNDATION FEATURES LIGHT SHEET MICROSCOPY PROJECT

A multidisciplinary team featuring researchers from biology, biomedical engineering, optics, and GIDS-AI is developing an innovative microscopy resource on campus, allowing for cutting-edge scientific research in biological imaging. Thanks to support from the Arnold and Mabel Beckman Foundation, researchers are advancing their new FIRE light-sheet microscopy configuration. Watch a video by the Beckman Foundation describing the project.
MASTER’S EARLY ADMISSION PATHWAY INFO SESSION FRIDAY
The Hajim School is introducing a new opportunity for students to receive guaranteed admission into one of the University of Rochester’s master’s programs and graduate within 2 semesters. The Master’s Early Admission Pathway (MS-EAP) is available for students in their junior year of an undergraduate program in the Hajim School who have a GPA of 3.5 or higher. Eligible students have the option of gaining early admission into a master’s program within the Hajim School or the Simon Business School.
The Office of Graduate Education and Postdoctoral Affairs will host an information session for students interested in learning more about the program, how to apply, and the career benefits of a master’s degree from 3-4 p.m. on Friday, November 14 in 202 Gavett Hall. They will serve free donuts and drinks. Register online.
AUTHORSHIP WORKSHOP
Students who are curious about authorship models in STEM disciplines or want to learn how to have difficult conversations around collaboration and credit are invited to a workshop from 3:30 to 4:30 p.m. on Friday, November 14 in Rettner Hall. The event is the first in a series of authorship workshops, which will include humanities authorship conversations, handling, authorship disputes, and more. The event is hosted by the Office of Undergraduate Research in collaboration with the Office of Academic Integrity; the Office of Research Integrity, Stewardship, and Ethics; and the Office of Graduate Education and Postdoctoral Affairs. Register to attend.
GAMING FOR ALL: A WOMEN IN GAMES CELEBRATION
The Strong National Museum of Play will host Gaming for All: A Women in Games Celebration from 6-9 p.m. on Thursday, November 13. The event celebrates the contributions of women, BIPOC, LGBTQIA+ communities, people with a disability, and other groups to the world of video games! The evening kicks off in The Strong’s Paychex Theater at 6:15 p.m. for powerful micro talks and a panel featuring trailblazers from the video game industry.
The Digital Media Studies Program will cover admission for the first 19 students to RSVP via this form by Wednesday, November 12.
LEVERAGING BLACKBOARD AND HELIOCAMPUS FOR EFFECTIVE EVALUATION
The Rochester Year One series, which supports new and early-career faculty in their professional development, will host an assessment essentials workshop from noon to 1:30 p.m. on Thursday, November 13 in the Rush Rhees Library Gamble Room 361.
The workshop will delve into the process of aligning and measuring student learning outcomes across different levels: courses, programs, and accreditation standards. The presenters will discuss how the use of technology can supplement existing practices to streamline data collection and documentation within the assessment cycle. The presentation will also show examples of how tools like BlackBoard and HelioCampus can be harnessed to track student performance longitudinally, aid in program reviews, and meet accreditation benchmarks. You can RSVP on the Provost’s website.
Have a great week!
Your dean,
Wendi Heinzelman